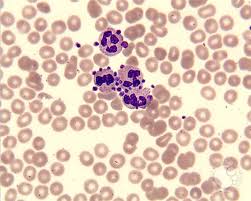

عند إجراء تحليل دم للمريض
CBC
قد تُظهر لنا النتيجة
انخفاض معدل الصفائح الدمويه في الدم
ولكن عند إجراء
Blood smear
لنفس العينه نجد الصفائح الدمويه متجمعه حول النيوتروفيل مماتسبب في قراءه خاطئة
بالتالي
False thrombocytopenia
😶
CBC
قد تُظهر لنا النتيجة
انخفاض معدل الصفائح الدمويه في الدم
ولكن عند إجراء
Blood smear
لنفس العينه نجد الصفائح الدمويه متجمعه حول النيوتروفيل مماتسبب في قراءه خاطئة
بالتالي
False thrombocytopenia
😶
جاري تحميل الاقتراحات...